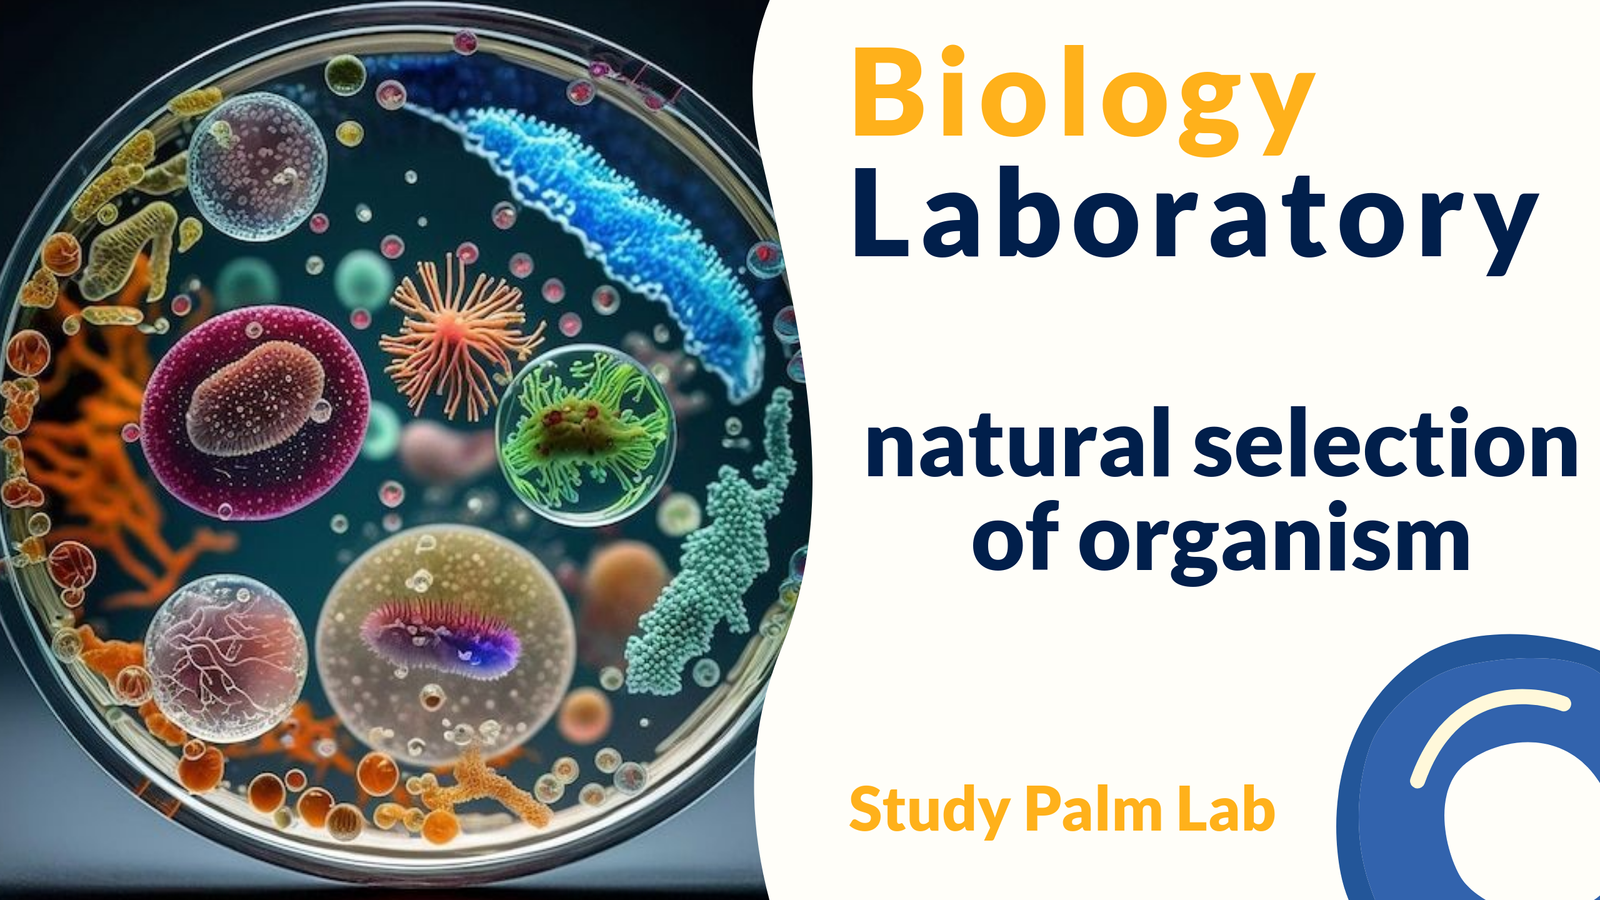
Natural Selection Of Organism

Available Simulations


Calculus-grapher laboratory
Integration and differentiation graph's of different functions
Start Simulation
mean, share and balance in statistics
This experiment help students to understand Statistics very well
Start Simulation
Simple Harmonic : masses and springs
This experiment give a deep understanding to students about Simple harmonic motion
Start Simulation

Natural Selection Of Organism
This Is the Biology experiment the natural selection of organism
Start Simulation
Understand pH Measurement
This exeriment help students to understand Ph measurement in deep
Start Simulation
Simple projectile motion
This is a simplest way of understanding the effect of gravity in motion of object in air.
Start Simulation


Building an Atom
With this experiment help a student to know the composition of an Atom
Start Simulation

Density Experiment
This experiment help students to understand the basic of Density
Start Simulation
Biology Photosynthesis simulation
This simulation show the effect of different condition that affect the ability of the plant to make its own food
Start Simulation